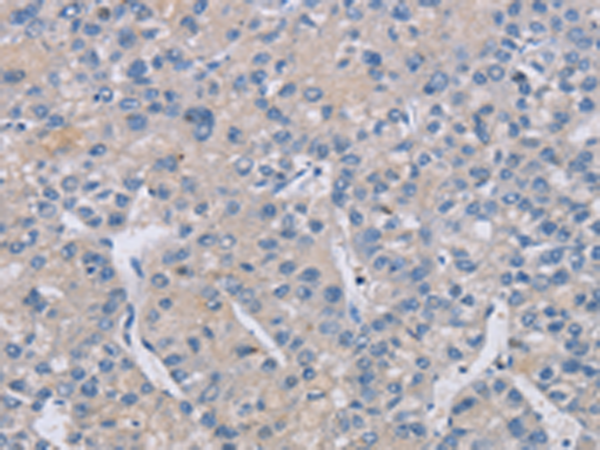

中文名稱(chēng): 兔抗CREBZF多克隆抗體
|
Background: |
Host cell factor (HCF) is a cellular cofactor required for the activation of VP16 which expresses the herpes simplex virus immediate early gene. V16 binds to HCF through a 4-amino acid motif similar to the HCF binding domain of the basic leucine-zipper proteins Luman and Zhangfei (ZF). Luman activates promoters containing cAMP or unfolded protein response elements (UPRE). Zhangfei suppresses the transcriptional activity of Luman, but requires HCF binding which may target Luman and Zhangfei to a common location. Sequence analysis predicts that the deduced 272-amino acid Zhangfei protein has a negatively charged N terminus, a leucine zipper of 6 heptad leucine repeats separated by a conserved 6-amino acid spacer, a basic domain, and a bZIP region. It is also presumed that the N-terminal acidic region of Zhangfei is an activation domain. |
|
Applications: |
ELISA, WB, IHC |
|
Name of antibody: |
CREBZF |
|
Immunogen: |
Synthetic peptide of human CREBZF |
|
Full name: |
CREB/ATF bZIP transcription factor |
|
Synonyms: |
ZF; SMILE |
|
SwissProt: |
Q9NS37 |
|
ELISA Recommended dilution: |
2000-5000 |
|
IHC positive control: |
Human liver cancer |
|
IHC Recommend dilution: |
25-100 |
|
WB Predicted band size: |
37 kDa |
|
WB Positive control: |
Mouse brain tissue and PC3 cells |
|
WB Recommended dilution: |
500-2000 |

購(gòu)物車(chē)
購(gòu)物車(chē) 幫助
幫助
 021-54845833/15800441009
021-54845833/15800441009
